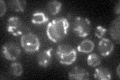
YPR058W
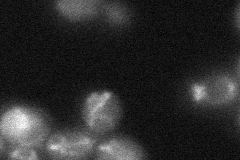
YPR058W
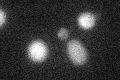
YPR058W
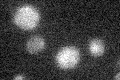
YPR058W

View description
Mitochondrial protein, putative inner membrane transporter with a role in oleate metabolism and glutamate biosynthesis; member of the mitochondrial carrier (MCF) family; has similarity with Ymc2p
Localization:
Intensity:
Fold change:
Significance:
-
C’ GFP library in SD
mitochondria17.11 -
N' NOP1pr-GFP in SD

mitochondria190.789 -
N' TEF2pr-mCherry in SD

mitochondria182.786 -
N' NATIVEpr-GFP in SD

mitochondria22.5782 -
N' TEF2pr-VC and Cyto-VN in SD
mitochondria33.0288 -
C’ GFP library in SD+DTT
cytosol12.760.74No -
C’ GFP library in SD+H2O2

vacuole19.311.12No -
C’ GFP library in Starvation Media
cytosol15.590.91No -
C’ GFP library on the background of Pup2-DaMP

mitochondria -
C’ GFP library on the background of CCT mutant

mitochondria17.87871.0438No
